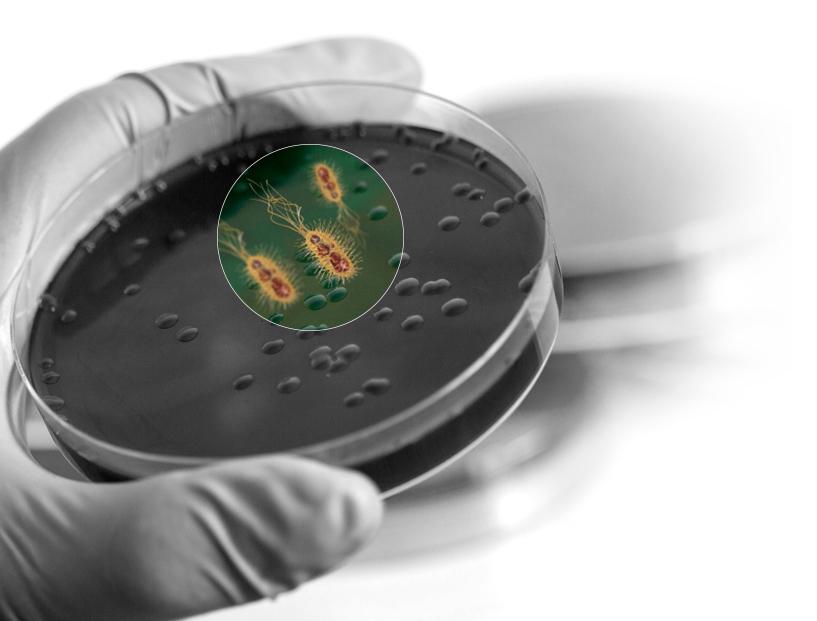
trs BioDevulc

YOUR PARTNER FOR
SMART SOLUTIONS
Fusing sustainability and smart solutions with optimal quality standards and high marketability, for a positive ecological footprint.

TRS can produce different grades of TyreXol™ by varying the feedstock, the grinding technology, the particle size and the treatment of the rubber particles.
The end application technical and commercial requirements will dictate which technology to use.

A game-changing biochemical process for surface devulcanization of the rubber powder.


![]()
